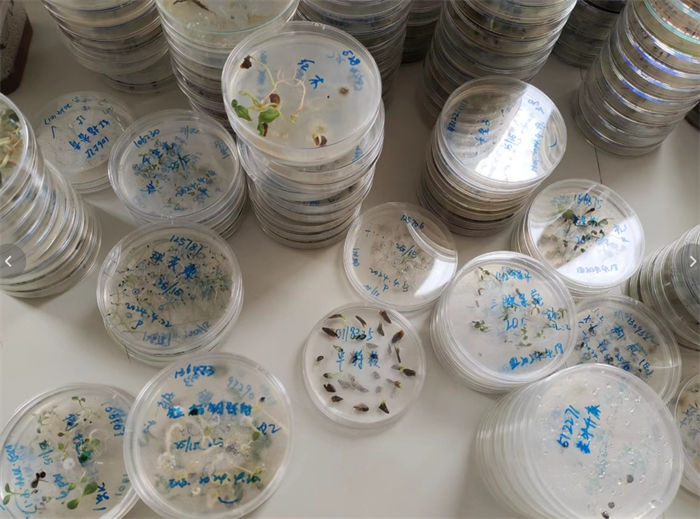
8503628b0b39427d8635fee0aff01e2e.png

中國西南野生生物種質資源庫種子萌發(fā)、野生植物果實、種子展示。魏敏 攝
走進中國科學院昆明植物研究所(以下簡稱“昆明植物所”)中國西南野生生物種質資源庫(以下簡稱“種質庫”)實驗室,記者們被眼前擺放的瓶瓶罐罐吸引了目光和腳步,紛紛圍上前拍照,還未等種質庫保藏中心主任蔡杰開始介紹,便拋出一個又一個問題,蔡杰風趣幽默地一一接招。
這些在記者看來平平無奇的干枯植物,對蔡杰來說如生命般寶貴。昆明植物所的科學家們傾注了大量心血,致力于生物多樣性的異地保護工作。他們收集、保藏、研究和共享各種生物的遺傳資源,為云南這片生物多樣性的寶庫中的眾多野生生物種質資源提供了一個安全的避風港,就如同一個現(xiàn)代版的“諾亞方舟”。
日前,記者走進昆明植物所,近距離觀察科學家們依托種質庫開展生物多樣性保護、收集、保藏與研究工作。
種質庫由中國科學院和云南省共建,昆明植物研究所管理,是我國第一個以野生生物種質資源保存為主的綜合保藏設施,它也是亞洲最大、全球第二的野生生物種質資源庫,與英國“千年種子庫”、挪威“斯瓦爾巴全球種子庫”等一起成為全球生物多樣性異地保護的主要設施。截至2023年12月,種質庫已收集保存各類野生生物種質資源約2.7萬種30萬余份。
如此大量的野生生物種質資源是如何保藏的?蔡杰帶著記者來到存放種子的冷庫前,說道:“為了長期存放大量野生植物的種子,這間冷庫溫度是零下20攝氏度?!?/p>

中國西南野生生物種質資源庫冷庫。魏敏 攝
這一排排碼放整齊、貼著標簽的小罐子中保存的,便是來自全國的科研人員們在十多年間收集保藏的野生植物種子,它們的珍貴不言而喻。科研人員對它們的珍視不是靜止的,而是動態(tài)的,基于這些野生植物種子,科學家們展開了系統(tǒng)的科學研究。建庫以來,培育珍稀食用菌(羊肚菌、球蓋菇)、高檔花卉(兜蘭、杓蘭)新種質、新技術,成為中國科學院鄉(xiāng)村振興典型幫扶模式之一;開發(fā)的生物農藥,應用于線蟲防治成效顯著。既為綠色生產力邁向新質生產力蹚出了一條新路,探索出一條生物多樣性保育、資源持續(xù)利用與民生發(fā)展相結合的道路,也為全球生物多樣性保護和惠益分享提供了中國案例。
云南被譽為“植物王國”,擁有豐富的植物資源。為了充分挖掘這些資源的潛力,依托種質庫建設的“國家重要野生植物種質資源庫”,成為我國31個國家生物種質與實驗材料資源庫之一。昆明植物所還構建了植物分子生物學和基因組學的技術體系和研究平臺。作為該所的重要組成部分,多個野外臺站和研究平臺在提供野生生物種質資源的同時,還能通過網絡上傳或獲取平臺的數據,實現(xiàn)信息的互聯(lián)互通和實時共享。這為植物資源的開發(fā)利用和多領域科研成果的取得提供了有力支撐。
以野外臺站為例,“我們借助在滇西北廣泛布設的樣地體系和加入國家監(jiān)測網絡聯(lián)網研究,深入挖掘并系統(tǒng)性地開展生物多樣性的監(jiān)測與保護研究。”麗江森林生物多樣性國家野外科學觀測研究站(以下簡稱“麗江站”)常務副站長許琨向記者介紹道,言語間充滿對生物多樣性監(jiān)測與保護這份事業(yè)的熱愛與執(zhí)著。
麗江站是隸屬中國科學院昆明植物研究所的國家級野外臺站,站內海拔跨度千米有余,自然形成了一座活生生的生物多樣性實驗室,其獨特的垂直帶譜宛如自然界精心鋪陳的探索迷宮。麗江站的科研團隊經過十多年的觀測,獲得了大量長期、定位、連續(xù)、具有自主知識產權的第一手觀測數據,目前收集保存了滇西北地區(qū)2600余種重要野生植物種質資源,為種質庫活體圃提供了重要的基礎數據。
“環(huán)境異質性和地形多樣性是造就生物多樣性的主要原因,而生物多樣性是維系生態(tài)系統(tǒng)穩(wěn)定及其功能的首要條件?!钡蠎c白馬雪山高山冰緣生態(tài)系統(tǒng)野外科學觀測研究站(以下簡稱“白馬站”)常務副站長楊揚研究員如是說,在這里,每一片葉子、每一抔土壤都孕育著生命的奇跡與無限可能。
除了麗江站,白馬站也是野生植物種質資源的重要基礎數據來源地。站區(qū)占地30畝,海拔3800至4300米,擁有豐富的植物資源,不同的海拔高度范圍往往生長著不同的植物?!拔覀兛吹侥撤N植物,往往便知道當前處于的海拔高度或地形。如中國十大名花綠絨蒿,往往盛開在環(huán)境特別惡劣、人跡罕見,海拔四五千米以上的流石灘。當走在都是碎石的高山上,腳步特別沉,呼吸特別重,看到這么漂亮的花時,感覺會特別不一樣?!睏罡闭鹃L的話也讓記者進一步理解了生物多樣性的意義。生物多樣性保護與我們每一個人都密切相關,它不僅僅是避免某種生物滅絕,更是讓生物的觀賞價值、經濟價值、藥用價值等惠益更多人。
生物多樣性的保護不僅倚賴于科學家的堅守,更需要全社會提升保護意識,加入到保護行列中,促進生物多樣性保護工作不斷取得新的進展和成就?!袄ッ髦参锼劳凶陨淼目蒲衅脚_、科學植物園和野外臺站,已建立起比較完善的科普教育與研學機制,如以‘扶荔宮’溫室群為核心的聯(lián)合國生物多樣性締約方第15次會議永久性成果展示點,是云南省獨具歷史文化底蘊、科學內涵豐富的生物多樣性研究、保護與科學教育基地?!崩ッ髦参锼h委書記、副所長李宏偉說道,“希望在我們的努力下,越來越多的青少年加入到生物多樣性保護行列中來,不斷推進這項事業(yè)取得更多的成果?!保ā皩W習強國”記者魏敏)
下一篇:數字化時代下非遺保護與傳承的路徑
運營機構:鄂爾多斯國家級文化和科技融合示范基地管委會
Email:ordoswh123@163.com 服務電話:0477-8394929